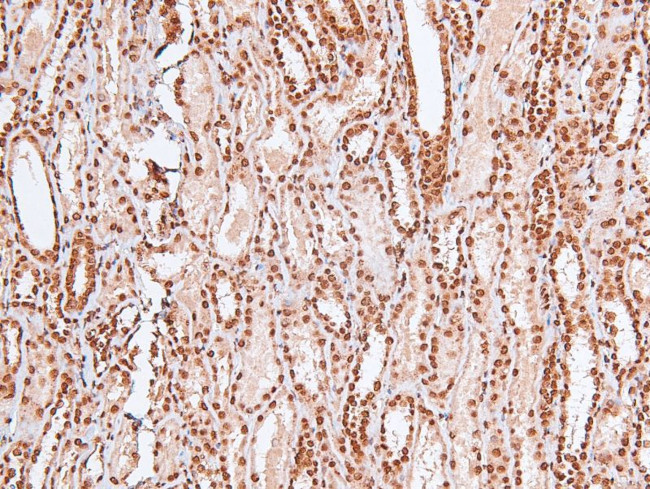
Phospho-MARK Pan (Thr215) Antibody in Immunohistochemistry (Paraffin) (IHC (P))

Search
Invitrogen
Phospho-MARK Pan (Thr215) Polyclonal Antibody
{{$productOrderCtrl.translations['antibody.pdp.commerceCard.promotion.promotions']}}
{{$productOrderCtrl.translations['antibody.pdp.commerceCard.promotion.viewpromo']}}
{{$productOrderCtrl.translations['antibody.pdp.commerceCard.promotion.promocode']}}: {{promo.promoCode}} {{promo.promoTitle}} {{promo.promoDescription}}. {{$productOrderCtrl.translations['antibody.pdp.commerceCard.promotion.learnmore']}}
图: 1 / 4
Phospho-MARK Pan (Thr215) Antibody (PA5-105814) in IHC (P)




Please note: We are reviewing Western blot images included in the antibody testing data in our catalog, including those provided by third parties. Unless expressly labeled or annotated as “raw-unedited”, Western blot images included in the antibody testing data in our catalog may have been edited, optimized or otherwise adjusted for presentation.
产品信息
PA5-105814
种属反应
宿主/亚型
分类
类型
抗原
偶联物
形式
浓度
规格
纯化类型
保存液
内含物
保存条件
运输条件
RRID
产品详细信息
Antibody detects endogenous levels of MARK1/2/3/4 only when phosphorylated at Thr215.
靶标信息
MARK1 (MAP/microtubule affinity-regulating kinase 1) belongs to the MARK family of serine/threonine kinases. MARK family protein kinases phosphorylate microtubule-associated proteins and may play a role in cytoskeletal stability. MARK2 refers to MAP/microtubule affinity-regulating kinase 2 isoform a [Homo sapiens]. EMK (ELKL Motif Kinase) is a small family of ser/thr protein kinases involved in the control of cell polarity, microtubule stability and cancer. Several cDNA clones have been isolated that encoded two isoforms of the human ser/thr protein kinase EMK1 called MARK2. MARK3 was originally identified as a marker that was induced by treatment with DNA damaging agents, and loss of MARK3 was found with carcinogenesis in the pancreas. MARK4 contains an N terminal serine/threonine kinase domain, a central ubiquitin associated domain, and a C terminal KA1 associated kinase domain. RT PCR analysis detects upregulated expression of the gene for MARK4 in nearly all clinical hepatocellular carcinoma cells.
仅用于科研。不用于诊断过程。未经明确授权不得转售。
篇参考文献 (0)
生物信息学
蛋白别名: C-TAK1; Cdc25C-associated protein kinase 1; cTAK1; ELKL motif kinase 1; ELKL motif kinase 2; ELKL motif serine-threonine protein kinase 3; ELKL motif serine/threonine-protein kinase 3; EMK-1; EMK-2; EMK1; EMK2/MARK3 serine-threonine protein kinase; MAP/microtubule affinity-regulating kinase 1; MAP/microtubule affinity-regulating kinase 2; MAP/microtubule affinity-regulating kinase 3; MAP/microtubule affinity-regulating kinase 4; MAP/microtubule affinity-regulating kinase 4L; MAP/microtubule affinity-regulating kinase-like 1; mark1; mark1 {ECO:0000312|RGD:619882}; mark2 {ECO:0000312|RGD:708483}; MARK4 serine/threonine protein kinase; MPK-10; Par-1a; Par-1b; Par-1c; PAR1 homolog; PAR1 homolog b; PAR1 homolog c; Protein kinase STK10; Ser/Thr protein kinase PAR-1; serine/threonine kinase; Serine/threonine-protein kinase MARK1; Serine/threonine-protein kinase MARK2; Serine/threonine-protein kinase p78
基因别名: 1600015G02Rik; 2410090P21Rik; A430080F22Rik; AW491150; B930025N23Rik; C-TAK1; C79806; CTAK1; Emk; EMK-1; EMK1; EMK2; Emk3; ETK-1; ETK1; KIAA1477; KIAA1860; MARK; MARK1; MARK2; MARK3; MARK4; MARKL1; mKIAA1477; mPar-1c; MPK10; Par-1; Par-1b; Par-1c
UniProt ID: (Mouse) Q8VHJ5, (Rat) O08678, (Rat) O08679, (Mouse) Q05512, (Rat) Q8VHF0, (Mouse) Q03141, (Mouse) Q8CIP4
Entrez Gene ID: (Mouse) 226778, (Rat) 117016, (Rat) 60328, (Mouse) 13728, (Rat) 170577, (Mouse) 17169, (Mouse) 232944, (Rat) 680407